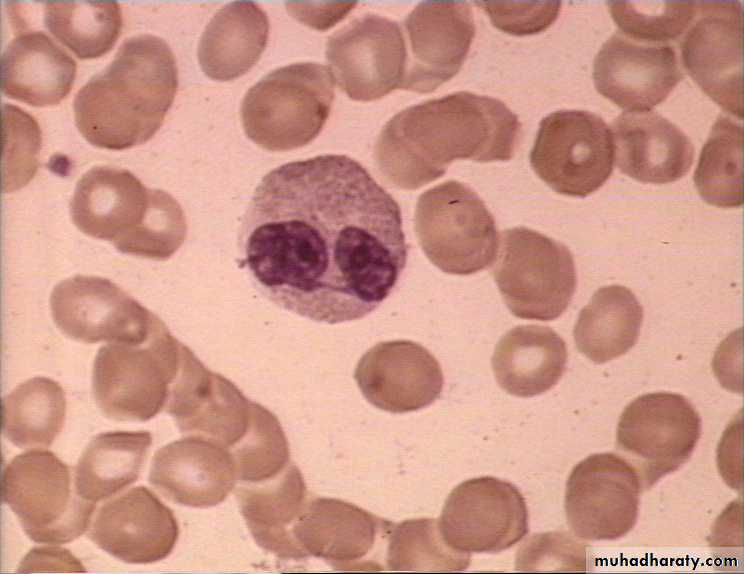
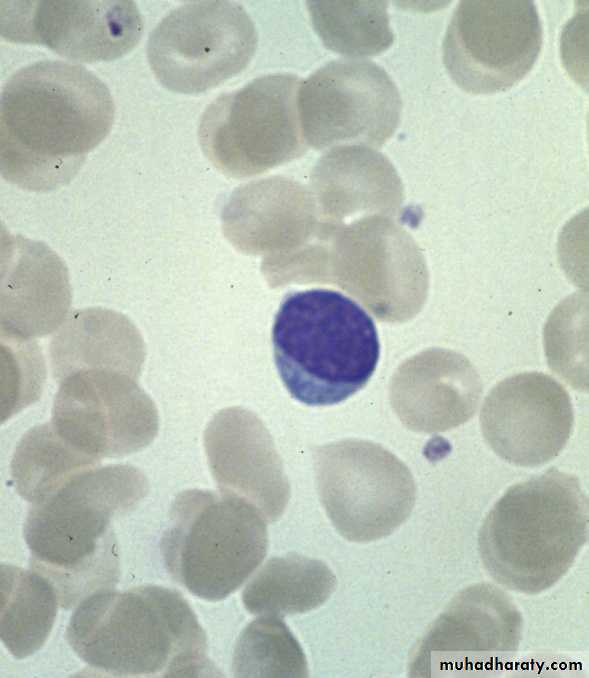
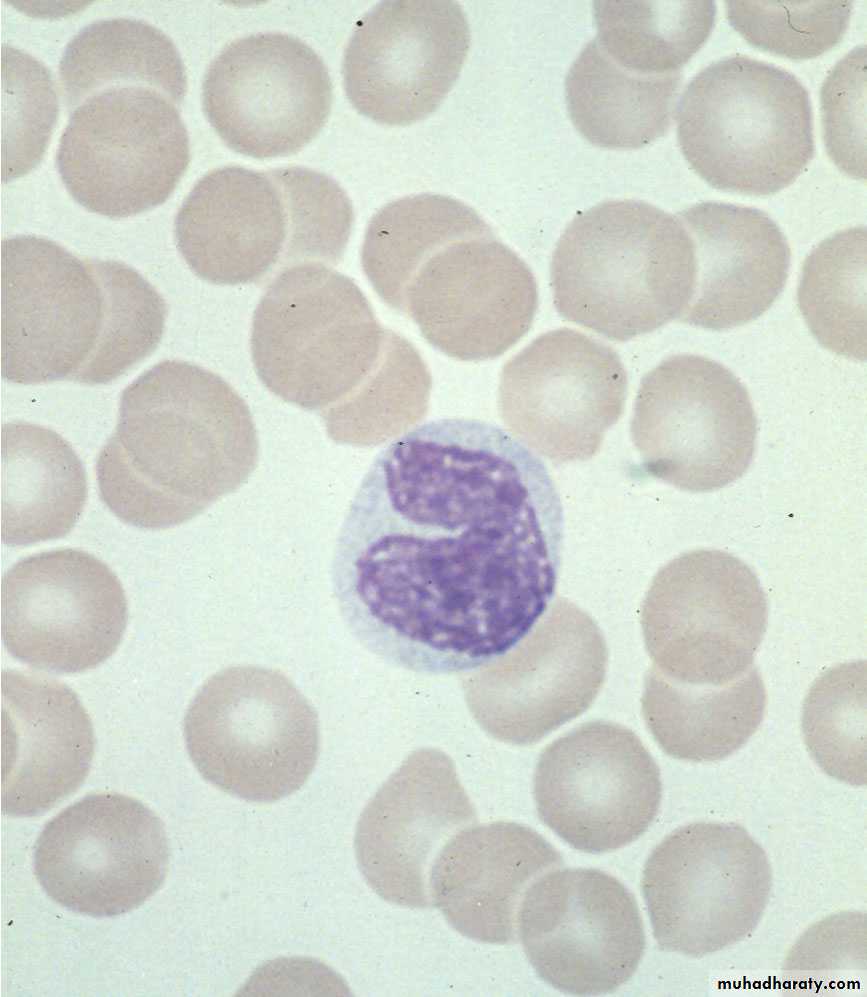
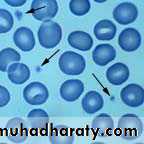

Ganglia
Ovoid structures containing neuronal cell bodies and glial cells supported with C.T.There are two types:
• Sensory (spinal) ganglia.
• Autonomic (sympathetic) ganglia.
.
• Found along dorsal root of spinal nerve.
• Ganglion cells are arranged in groups .
• Ganglion cells are rounded with centric N.
• Satellite cells surround Ganglion cells with large number .
• Neuron are pseudo-unipolar.
• Lipochrome granules lie beside the nucleus,
• Found along autonomic nerve.
• Ganglion cells are randomly arranged.
• Ganglion cells are irregular in shape with eccentric N.
• Satellite cells are less in number .
• More than one type
• Lipochrome granules near cell membrane.
SPINAL G.
AUTONOMIC G.
Sensory (Spinal ) Ganglia
Ganglion cell
nucleusnucleolus
Satellite cell
Autonomic (Sympathetic) Ganglion
nucleus
Ganglion cellSatellite cell
fibroblast
nucleolus
Basophil